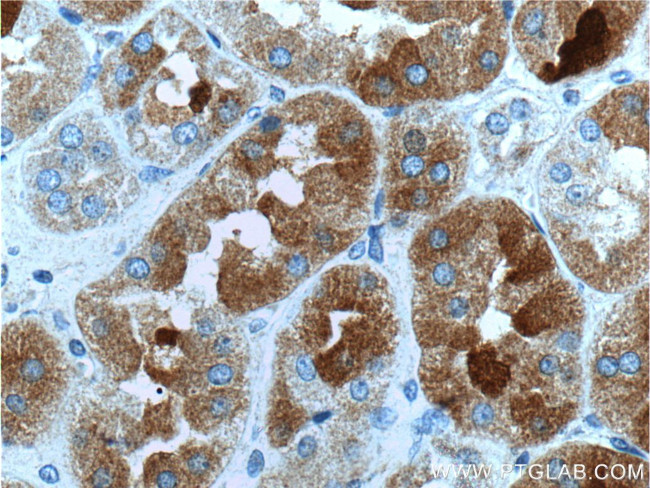
GHRHR Antibody in Immunohistochemistry (Paraffin) (IHC (P))
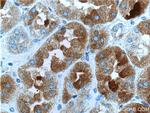
GHRHR Antibody in Immunohistochemistry (Paraffin) (IHC (P))

Search
Proteintech
GHRHR Polyclonal Antibody
{{$productOrderCtrl.translations['antibody.pdp.commerceCard.promotion.promotions']}}
{{$productOrderCtrl.translations['antibody.pdp.commerceCard.promotion.viewpromo']}}
{{$productOrderCtrl.translations['antibody.pdp.commerceCard.promotion.promocode']}}: {{promo.promoCode}} {{promo.promoTitle}} {{promo.promoDescription}}. {{$productOrderCtrl.translations['antibody.pdp.commerceCard.promotion.learnmore']}}
产品信息
20715-1-AP
种属反应
宿主/亚型
分类
类型
抗原
偶联物
形式
浓度
规格
纯化类型
保存液
内含物
保存条件
运输条件
产品详细信息
The antibody is specific to GHRHR.
靶标信息
Growth Hormone Releasing Hormone (GHRH) is a member of a family of peptide hormones that also includes VIP (vasoactive intestinal polypeptide) and PACAP (pituitary adenylate cyclase-activating polypeptide). It is a hypothalamic peptide that binds to G-protein coupled receptors to stimulate secretion and synthesis of growth hormone (GH). GHRH receptor proteins have been identified on the plasma membrane of primary human tumor cells, and are thought to be involved in the growth of a variety of cancer cells.
仅用于科研。不用于诊断过程。未经明确授权不得转售。
篇参考文献 (0)
生物信息学
蛋白别名: G-protein coupled receptor; GHRH receptor; Ghrh-r; GHRHRpsv; GRF receptor; GRFR; Growth hormone - releasing receptor; Growth hormone-releasing factor receptor; Growth hormone-releasing hormone receptor
基因别名: GHRFR; GHRHR; GHRHREC; GRFR; IGHD1B; IGHD4; lit; little
UniProt ID: (Human) Q02643, (Rat) Q02644, (Mouse) P32082
Entrez Gene ID: (Human) 2692, (Rat) 25321, (Mouse) 14602